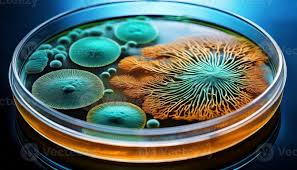

Our Science
Certified Lion's Mane clinically proven to boost cognition...create new brain cells!
Lion’s Mane is one of nature’s most powerful ingredients for brain health. Its bioactives (hericenones and hericines) promote Nerve Growth Factor (NGF) - essential for the growth and repair of neurons.
We use a proprietary Finnish biotech extraction - the only EFSA-approved method - achieving 95% bioavailability (vs. ~5% with water extraction or ~50% with dual extraction). That means more of the good stuff: hericenones and erinacines.


Hericenones and Erinacines
Igniting Cognitive Renewal
Our Lion's Mane is grown to have high concentration of Hericenones and Erinacines the main bio-active ingredient supporting cognitive function by stimulating the production of:
- Nerve Growth Factor (NGF) and
- Brain-Derived Neurotrophic Factor (BDNF)
These two molecules are essential for brain health. This activation promotes neurogenesis, strengthens synaptic plasticity, and helps protect neurons from stress and age-related decline. Together, these mechanisms contribute to improved focus, memory, learning capacity, and overall cognitive resilience.

Beta Glucans
Building Immunity
Our Lion's mane is standardised for active Beta 1,3/1,6-glucans which:
- Strengthen immune function by activating key immune cells such as macrophages and NK cells.
- Support gut health through prebiotic activity that nourishes beneficial microbiota.
- Reduce inflammation by modulating immune signalling pathways.
- Enhance overall resilience, helping the body maintain balance during stress and recovery.
Why is our Lion's Mane superior?
-

Standardised Extracts
Our extract is standardised not only for active Beta 1,3/1,6-glucans—the specific polysaccharides shown in research to support immune signalling and gut–immune communication—but also for the neuroactive compounds that give Lion’s Mane its cognitive reputation: hericenones and erinacines. Standardising across both immune-modulating and cognitive-supporting bioactives ensures a consistently potent extract that delivers the full spectrum of Lion’s Mane benefits
-

Bioavailability over dose
95% Bioavailability. Bioavailability simply means how much of an ingredient your
body can truly access/use. Most Lion’s Mane extracts release only ~5% of their
bio actives with water extrusion (or ~50% with dual extraction). Our Ultrasonic
extraction unlocks up to 95%, using the only approved ultrasonic method in the
EU and UK - giving you far more of the mushroom’s beneficial compounds. -

Rigorous testing
Certificate of AnalysisEach batch is independently tested and standardised, offering a level of precision,
consistency and integrity rarely found in the mushroom category. This is vastly different from other Lion's mane extracts mixed with grain. See our Certificate of Analysis (CoA).
Results from Clinical trials show
- All-natural Caffeine-free alternative without the “crash” phenomenon or jittery side effects you may experience from caffeine†
- Supports an increase in alertness and sustain alertness up to 5 h
- Provides sustained mental energy solution you can feel
- No interference to your sleep cycle
- Does not increase base heart rate

How does it work?
Made from a proprietary extract of Alpinia galanga, enXtra targets a cognitive process known as “Attention Network Function” (ANF), which is the ability of the brain to allocate processing resources to a specific task. The ANF system plays a critical role in mental alertness and the ability to focus on a task.
Mechanism of action: A molecular docking study of enXtra demonstrated that its phytoconstituents may interact with neurotransmitters such as dopamine and acetylcholinesterase that play a role in alertness and focus.
powerful medicinal herbs such as dandelion, chicory and carob have been used since ancient times

Lion's Mane

Dandelion Root
| CLAIM / STUDY | RESOURCE |
|---|---|
| Improvement in liver function associated with restoring histopathology of the liver cells. | https://efsa.onlinelibrary.wiley.com/doi/10.2903/j.efsa.2009.1218 |
| Dandelion prevents liver fibrosis, inflammatory response, and oxidative stress | https://link.springer.com/article/10.1186/s41936-020-00177-9 |
| Dandelion helps normalise blood sugar levels. | https://pmc.ncbi.nlm.nih.gov/articles/PMC5553762/ |

Chicory
| CLAIM / STUDY | RESOURCE |
|---|---|
| Chicory offers an anti-inflammatory, antimicrobial, antioxidant, hypolipidemic and hypoglycemic effect and also an important role in appetite regulation. | https://www.mdpi.com/2072-6643/14/5/957 |
| Chicory affects bowel function, benefits butyrogenic trophic chains, and promotes glycaemic control. | https://www.cambridge.org/core/journals/gut-microbiome/article/dried-chicory-root-improves-bowel-function-benefits-intestinal-microbial-trophic-chains-and-increases-faecal-and-circulating-short-chain-fatty-acids-in-subjects-at-risk-for-type-2-diabetes/6209AEAFBDDB181197F22AE24388186B |
| Chicory roots possess anti-inflammatory activity, inhibiting various cytokines, their antioxidant effects, and their free radical scavenging activity | https://journals.lww.com/asol/fulltext/2014/34010/Anti_inflammatory_activity_of_roots_of_Cichorium.8.aspx |
| Chicory as a rich and versatile source of complex dietary fibers opens to combat a range of chronic metabolic diseases in fiber-poor diet. | https://pmc.ncbi.nlm.nih.gov/articles/PMC7360457/ |
| Chicory: Understanding the Effects and Effectors of This Functional Food | https://www.mdpi.com/2072-6643/14/5/957 |
| Role of short chain fatty acids in gut health and possible therapeutic approaches in inflammatory bowel diseases | https://www.wjgnet.com/2307-8960/full/v10/i28/9985.htm |

Alpinia Galanga
| CLAIM / STUDY | RESOURCE |
|---|---|
| Enxtra (Alpinia Galanga) leads faster and more focused processing of information with an improvement inthe brain’s ability to concentrate for longer periods of time. | https://www.tandfonline.com/doi/epdf/10.2147/OAJCT.S164450?needAccess=true |
| Alpinia Galanga improves alertness, accuracy, reaction time, and reduces errors in individuals. | https://www.proquest.com/openview/cb62df55474ba22ee85711e87e4bffc3/1?pq-origsite=gscholar&cbl=3933326 |
| Alpinia Galanga has powerful cytotoxic, antibacterial, and antioxidant properties. | https://www.cell.com/heliyon/fulltext/S2405-8440(24)13227-6 |

B Vitamins Mix
| CLAIM / STUDY | RESOURCE |
|---|---|
| B Vitamins contribute to cellular energy production translating into perceived relief from physical and mental fatigue as well as helping psychological and cognitive functions. | https://www.mdpi.com/2072-6643/12/1/228 |

Carob
| CLAIM / STUDY | RESOURCE |
|---|---|
| Carob enhances gut health specifically on both pathogenic and probiotic bacteria. | https://akjournals.com/view/journals/066/52/4/article-p612.xml |
| Carob contributes to improved metabolic health. | https://www.mdpi.com/2304-8158/11/14/2154 |
| Carob has outstanding functional properties and nutritional profile and is rich source of a plethora of bioactive components. | https://www.tandfonline.com/doi/full/10.1080/10942912.2022.2164590?scroll=top&needAccess=true#references-Section |
Each sip supports these pillars of health:
-
🦠Gut Health:
Supporting your gut's complex ecosystem is crucial for everything from immunity to mood to hormonal balance. Chicory, Dandelion root and Carob, all rich in prebiotic fibres, feed the good bacteria in your gut, making your gut microbiome healthier, thus improving digestion, enhancing immunity, and reducing inflammation in your gut.
-
🧠 Brain-Boosting without the cortisol spikes, anxiety or jitters
EnXtra, our clinically researched nootropic from the ginger family, gives sustained focus and attention without the crash, jitters or sleep disturbances.
-
🧹 Daily detoxification support:
Did you know that your liver is one of the hardest-working organs in our body? A sluggish liver can lead to everything from energy to hormonal issues. Support your body in flushing toxins as a part of daily detox routines with Dandelion, a powerhouse detoxifier.

No crash
Our coffee alternative is a super blend of functional herbs such

Caffeine free
Our coffee alternative is a super blend of functional herbs such

Nutritious
Our coffee alternative is a super blend of functional herbs such

Good for gut
Our coffee alternative is a super blend of functional herbs such
OUR RANGE OF HERBAL BLENDS